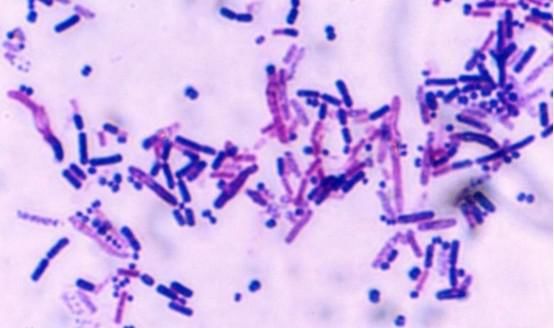
人类 人类为何找不到外星生命?新观点认为:人类一开始的想法就错了

人类 人类为何找不到外星生命?新观点认为:人类一开始的想法就错了
在科幻剧《星际迷航》中,曾经提到过这样一种可能性:人类只对地球上的生命和环境所有了解,然后参照地球去寻找宜居星球和地外生命,却忽视了一个问题,可能地外生命本身就和我们所知道的生命形式不同,所以,我们才会永远找不到它。
文章插图
人类真的是孤独的吗?
伴随着人类科学技术的发展,早在上世纪初,科学家们就开始寻找地外生命的痕迹,而当第二次世界大战结束之后,伴随着人类太空探索领域的全新发展,人类也开始尝试着去发出信号,和可能存在的外星文明取得联系。
同时,人类寻找地外生命的心情,也越来越迫切,不过,当时间流过,一次次的寻找最终都以失败告终,这也让科学家们产生了怀疑,宇宙中真的存在外星文明吗?或者说,除了地球之外,宇宙中真的还有生命存在吗?
文章插图
有观点认为,人类可能就是孤独的,而且地球上的生命也是,否则,我们又怎么会一直找不到地外生命呢?
不过,目前的主流观点仍然相信,地外生命也好,外星文明也好,都是存在的,而且非常普遍,人类没找到,只是方法不对,真的如此吗?
文章插图
新研究表明,人类还需要技术突破!
虽然人类诞生了200多万年的时间,但事实上人类真正意义上的科技发展,也不过几百年的时光,可想而知,在我们眼中看起来已经很厉害的科技,放在宇宙之中,对比其他可能存在的外星文明,只能说“啥也不是”。
科技上的不足,也限制了人类的思想,同时,也让我们无法找到地外生命。前段时间,日本和美国的联合而科学家爱团队通过研究,提出了一个新的观点:人类不应该将寻找地外生命的重点,放在用地球作为参考身上。
文章插图
在广袤的宇宙中,可能存在着拥有不同生物标志的生命体,而且它们的进化方式,也和地球生命不同,如果未来我们可以研发出一种全新的探测器,可以通过检测分析星球上特定的生命分子,这样一来,我们就有机会找到外星生命。
比方说,一些星球上,可能存在着复杂的有机混合物,而如果是按照人类过去的研究,则会将它们和生物区分开,然而事实上,这可能会直接导致我们错过了地外生命。
从时间上来看,很多科学家都认为,人类目前正处于寻找地外生命最关键的一个阶段,也是最难的一个阶段,大约需要几十年的时间,才可以彻底突破,而在突破之后,人类就会认识到宇宙中不同的生命形式,同时,可能在太阳系中,也会找到很多地外生命。
文章插图
太阳系也有地外生命吗?
当伽利略发明天文望远镜后,科学家们就开始通过它,探索更遥远的太空,同时,也观察我们周围的几颗星球——月球、火星、金星等等。
18世纪,有科学家在观察火星表面的时候,表示自己在上面发现了人工开凿的大运河,虽然这个发现并不准确,但也直接拉开了人类寻找外星生命的序幕。
随后,上世纪50年代末开始,伴随着美国和前苏联的“太空竞赛”,人类也开始发射探测器去往火星、月球和金星,在这个过程中,很多科学家也都是满怀希望,每一次都认为有可能找到外星生命,然而,每一次的探测,却都以失败告终。
文章插图
1976年,美国的“海盗2号”火星探测器,抵达火星后想要找到可能存在的火星生命,当然,而且它落地的地方,就是这一次“祝融号”着陆的乌托邦平原。
随后,NASA又发射了多个火星探测器抵达火星,包括今年最新抵达的“毅力号”,不过遗憾的是,过去的40多年时间里,除了研究认为火星存在过宜居期之外,并没有发现火星生命的痕迹。
不过,仍然有很多研究者相信,火星上是存在生命的,只不过,和我们想象中的复杂生命不同,火星生命可能只是古老的微生物化石。
文章插图
此外,NASA还计划,在2024年发射探测器去往木卫二,这也是太阳系中最被科学家们看到的另外一颗是什么星球。
【 人类|人类为何找不到外星生命?新观点认为:人类一开始的想法就错了】同时,在2027年的时候,NASA还计划探测土卫六,它同样也是一颗具有生命潜力的太阳系内星球,那么,你认为人类会在太阳系之内发现地外生命吗?欢迎说说你的看法!
推荐阅读
- 美国 时隔30多年,美国为何又想重访金星?
- 哥伦比亚大学 人类是否能够再造个地球环境,进行移民,生物圈2号告诉我们还是洗洗睡吧
- 诚实 中国首位女宇航员,为何返回后就没露面?原来一直在背后作奉献
- 咋样变得像立党一样优秀
- 杨紫 干最重的活、挨最狠的骂,陈赫李诞明明比杨紫干活多,为何被骂?
- 孕育 银河系中为何只有地球孕育出了生命这里告诉你答案
- 东方红一号 能量耗尽50年,东方红一号卫星为何还没坠毁它还能再飞100年
- 苏联 苏联当年要“挖穿地球”,却在挖到12263米时突然停手,为何?
- 大循环 淡水资源紧缺,为何不拦截长江和黄河自用,而是任其流入大海?
- 宇宙 理论上宇宙应存在大量文明,为何却没有文明联系我们,原因是什么?







